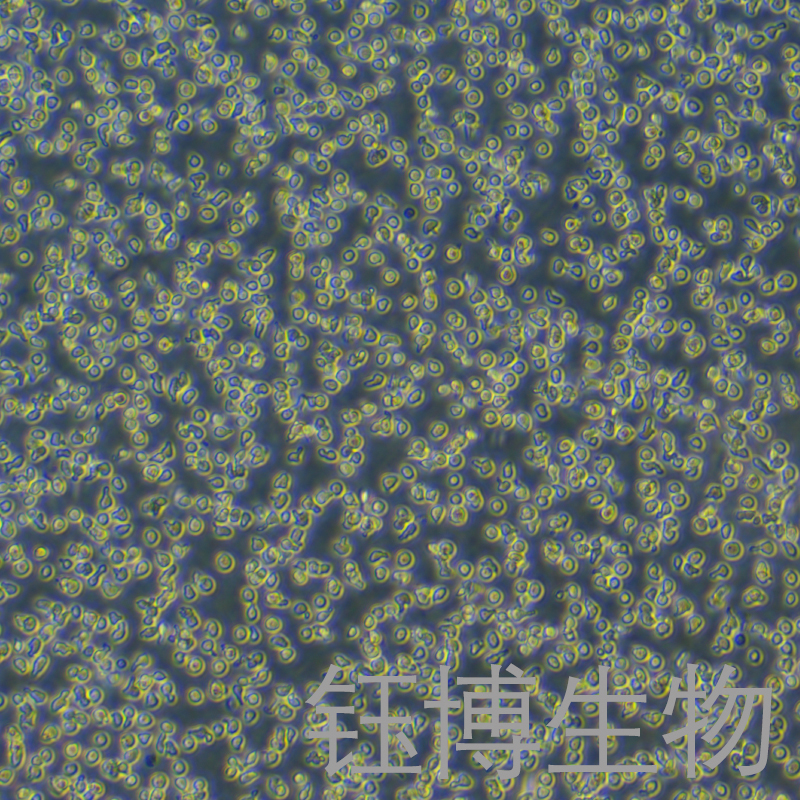
OCI-LY19（人B细胞淋巴瘤）YB-71829HC

OCI-LY19(人B细胞淋巴瘤)YB-71829HC
OCI-LY19
¥3150
1株
起订
上海 更新日期:2026-03-26
产品详情:
- 中文名称:
- OCI-LY19(人B细胞淋巴瘤)YB-71829HC
- 英文名称:
- OCI-LY19
- 品牌:
- YBio/钰博生物
- 产地:
- 中国/上海
- 保存条件:
- 常温
- 纯度规格:
- 99%
- 产品类别:
- 细胞系
- 种属:
- 人
- 组织:
- B细胞
- 细胞系:
- 肿瘤细胞
- 细胞形态:
- 淋巴母细胞样
- 生长状态:
- 悬浮生长
- 培养基:
- RPMI1640 +10% fetal bovine serum
- 冻存条件:
- 无血清冻存液,液氮储存
公司简介
上海钰博生物科技有限公司是2012年5月由“海归”组成的创业团队与两个专业投资机构发起成立的,以
开发生产科研试剂和特色检验产品为方向,经过两年多的努力,已经建立了免疫学和分子生物学的五个技术平台,开发了ELISA/ELISpot酶联免疫试剂盒、重组蛋白、荧光标记抗体、四聚体(Tetramer)特异性T细胞检测试剂盒、Aimplex流式高通量多因子检测、microRNA表达谱分析和功能研究等系列产品和服务,与国内外免疫学、干细胞、传染病和肿瘤研究及临床检验领域的科学家们建立了良好的合作关系,形成了一定的品牌影响力。钰博生物另建有七大技术服务平台(ELISA定制服务,免疫学检测服务、分子生物学技术服务、蛋白表达与纯化技术服务、抗体制备技术服务、细胞培养技术服务、整体实验课题服务。用专业的知识、专业的设备、专业的态度为客户提供一站式实验技术服务!
| 成立日期 | (12年) |
| 注册资本 | 200万人民币 |
| 员工人数 | 1-10人 |
| 年营业额 | ¥ 100万-300万 |
| 经营模式 | 工厂 |
| 主营行业 | 生化试剂,抗体,蛋白组学,分子生物学,细胞生物学 |
OCI-LY19(人B细胞淋巴瘤)YB-71829HC相关厂家报价 更多
-

- OCI-Ly19人弥漫大B淋巴瘤复苏细胞(附STR鉴定报告)
- 上海冠导生物工程有限公司 VIP
- 2026-07-02
- ¥1399
-

- OCI-LY19人B细胞淋巴瘤复苏细胞|送STR报告
- 上海宾穗生物科技有限公司 VIP
- 2026-07-02
- 询价
-

- 人B细胞淋巴瘤OCILy19,ATCC来源
- 上海晶风生物科技有限公司 VIP
- 2026-07-02
- ¥3500
-

- OCI-LY19人弥漫大B淋巴瘤细胞
- 上海雅吉生物科技有限公司 VIP
- 2026-07-02
- ¥1800
-

- 人B细胞淋巴瘤;OCILy19(STR鉴定正确)
- 上海雅吉生物科技有限公司 VIP
- 2026-07-02
- 询价
-

- 人B细胞淋巴瘤;OCI-LY19
- 上海抚生实业有限公司 VIP
- 2026-07-02
- ¥5000
-

- 人B细胞淋巴瘤;OCI-LY19
- 上海博湖生物科技有限公司 VIP
- 2026-07-01
- ¥5000
-

- OCI-LY19(人弥漫大B淋巴瘤细胞)
- 澳培赛生物科技(上海)有限公司 VIP
- 2026-07-01
- ¥3500
-

- OCI-LY19细胞(人弥漫大B细胞淋巴瘤细胞)LM8C1410
- 上海联迈生物工程有限公司 VIP
- 2026-01-28
- ¥3500
-

- OCI-LY19人B细胞淋巴瘤细胞库|培养基|带STR图谱
- 上海宾穗生物科技有限公司
- 2025-12-31
- 询价